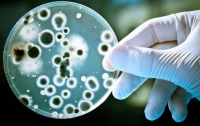
700 т воды из «гумпомощи» Путина могут нести опасность на молекулярном уровне

ВСЕ НОВОСТИ
-
16:28 Мир
Болгария отказалась пропускать российские самолеты с "гумпомощью" для Сирии
-
16:44 Общество
Минимум 5 млн граждан Украины нуждаются в гуманитарной помощи
Наиболее уязвимой группой являются люди, проживающие в районе так называемой "линии соприкосновения"
-
12:31 Общество
Пенсионеры Донбасса побили пропагандистов из России
Российские журналисты вынуждены были спасаться бегством от разъяренных пенсионерок, которые стояли в очереди за гуманитарной помощью от благотворительного фонда Рината Ахметова в Донецке.
-
15:56 Мир
Российскую помощь, в отличии от украинской, жители Донбасса не видят - бывший главарь террористов
Бывший лидер боевиков Игорь Стрелков/Гиркин заявляет, что российская гуманитарная помощь из-за нечистоплотности не доходит до жителей Донбасса в отличие от украинской.
-
07:25 Общество
Украина не обязана финансировать террористов - СНБО
Украина намерена и в дальнейшем предоставлять жителям восточных регионов страны гуманитарную помощь.
-
 14:45 Общество
14:45 Общество
Словакия прислала самолет гуманитарной помощи для бойцов АТО
Среди гуманитарной помощи – спальные мешки, обувь, дезинфицирующие средства, медицинские шины и носилки
-
 16:30 Экономика
16:30 Экономика
Южная Корея перечислит Украине $500 тысяч гуманитарной помощи
Гуманитарная помощь будет предоставлена через ООН и Международный комитет Красного Креста
-
 17:30 Политика
17:30 Политика
Лавров заявил, что Украина согласилась на второй гуманитарный груз
Глава МИД России заявил, что Украина дала согласие на доставку второго гуманитарного груза из России
-
16:00 Мир
Польша начала поддерживать украинскую армию
Польша предоставила украинской армии гуманитарную помощь, в соответствии с соглашением, которое две страны подписали 14 августа
-
 10:30 Общество
10:30 Общество
Города Донбасса уже получили 100 тонн украинской гуманитарной помощи
Помощь была частично распределена в районах Северодонецка и Лисичанска, на очереди Луганск
-
12:00 Происшествия
12:00 Происшествия
700 т воды из «гумпомощи» Путина могут нести опасность на молекулярном уровне
Употребление испорченной воды может очень негативно сказаться не только на здоровье, но и на умственной деятельности
-
 09:45 Мир
09:45 Мир
Польша планирует отправить в Украину гуманитарную помощь
-
 07:15 Общество
07:15 Общество
Россия решила помочь Украине солью, водой и воздухом
Зачем соль в регионе, где ее добывают и экспортируют — загадка
-
10:15 Общество
Представители ОБСЕ начнут осмотр «гуманитарного конвоя» РФ
-
 08:30 Общество
08:30 Общество
Ринат Ахметов запускает свой гуманитарный рейс
На пресс-брифинге было озвучено решение об открытии крупнейшей линии гуманитарной помощи в Донецкую и Луганскую области




